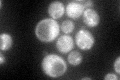
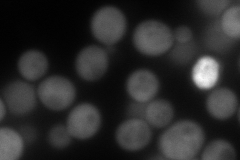
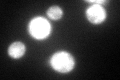
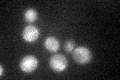

View description
Zinc metalloendopeptidase, found in the cytoplasm and intermembrane space of mitochondria; with Cym1p, involved in degradation of mitochondrial proteins and of presequence peptides cleaved from imported proteins
Localization:
Intensity:
Fold change:
Significance:
-
C’ GFP library in SD
cytosol66.46 -
N' NOP1pr-GFP in SD

cytosol169.6 -
N' TEF2pr-mCherry in SD
cytosol207.829 -
N' NATIVEpr-GFP in SD

nucleus25.6 -
N' TEF2pr-VC and Cyto-VN in SD

#N/A0 -
C’ GFP library in SD+DTT
cytosol88.081.32No -
C’ GFP library in SD+H2O2

cytosol72.761.09No -
C’ GFP library in Starvation Media
cytosol69.461.04No -
C’ GFP library on the background of Pup2-DaMP

cytosol -
C’ GFP library on the background of CCT mutant

cytosol100.9211.51822Yes
